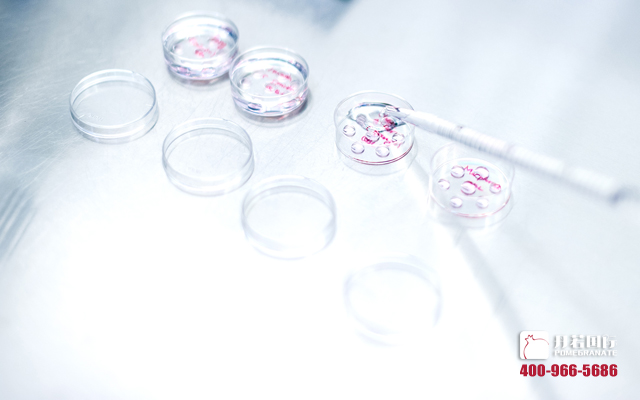

卵子取出之后,是否就万事大吉了?
时间:2017-07-11 09:45来源:丹若国际 点击:
次
卵子取出来,是不是就可以高枕无忧了?
正常情况下,只有成熟卵子才能顺利完成受精过程,在常规的试管促排卵治疗中,每个促排周期中的大多数卵子发育是同步的,大多数卵子可以成熟,但仍然有大约10%的不成熟卵子,这属于正常情况,一般不影响试管治疗!
但是,注意啦!有0.1~1%的少数患友,在促排中得到的卵子大部分是不成熟的,或是反复促排卵治疗中均无法获得成熟卵子,最终导致不孕。这种情况我们通常称之为卵子成熟障碍,其患者一般有原发不孕的临床特征。
那么究竟啥是卵子成熟障碍呢?
正常发育过程中,卵巢内的卵泡会经历从原始卵泡到初级卵泡、次级卵泡、窦前卵泡、窦卵泡以及最后排卵前卵泡这样一个过程,期间伴随着卵子的减数分裂和细胞质成分的积累。卵子从初级卵母细胞从生发泡期(germinal vesicle, GV)发育至MⅠ(metaphase I)期,在排卵前,卵子达到MⅡ期,完成成熟发育。
发生的原因
一切发生非偶然,事出必有妖!一般呢我们把它分为三个阶段:GV期阻滞,MI阻滞,MII阻滞。让我们来逐个分析一下原因!
GV期阻滞
减数分裂从阻滞于双线期的GV期卵子开始,首先其启动受成熟促进因子(maturation-promotingfactor, MPF)的激活调控; 第一次减数分裂的启动和进入中期的形态学标志是生发泡破裂(breakdown of the germinal vesicle, GVBD)。在动物模型中对促使 MPF 激活的关键调控事件的干扰可导致卵子阻滞在GVBD之前的阶段, 即通常说的GV 期阻滞。因此,卵子抑制阻滞在 GV 期的妇女,其MPF 激活信号转导途径存在缺陷。
MI阻滞
从第一次到第二次减数分裂需要发生染色体浓缩, 纺锤体形成,染色体排列在第一次减数分裂赤道板和同源染色体交会和分离,完成第一次减数分裂,即形成标志物第一极体(first polar body, Pb1)。卵子在Pb1 形成前发生阻滞, 即形态学上为MI阻滞。MI阻滞的发生可能是由于调节减数分裂进程的信号转导途径缺陷,也可能是纺锤体畸形导致。减数分裂过程中调节MI的关键酶是高度进化保守的, 且在 MII期和有丝分裂细胞周期中作用相似。因此,这些蛋白的遗传学缺陷,包括APC/C和分离酶,会导致胚胎期梗死而不只是MI阻滞。也许是卵子特异性的基因和蛋白表达上发生改变,如特异性补偿或调节关键调节子的蛋白表达变化,导致了临床上观察到的MI期阻滞。
MII阻滞
形态学分类为MII期卵子通常认为是“成熟卵子”,它阻滞在第二次减数分裂中期,并认为是具备受精能力的。但是,有些妇女产生的形态学上的MII卵子并不能受精形成胚胎。这种形态学的成熟度和受精能力不一致的现象可能是由于包含了处于Pb1形成和MII之间形态学分类的不成熟卵(这些卵子无受精能力)或卵子阻滞在MII期却不具备完成减数分裂的能力,受精缺陷也会产生相似的临床表现。
总之,卵子获得减数分裂能力的过程需要关键调控酶和信号转导分子的转录和翻译,这些因子间复杂的相互作用,决定了卵子是阻滞还是进行依赖于信号因子的生成和靶向降解间的微妙平衡。最终观察到卵子成熟阻滞是卵子在分子水平功能失调,导致的卵子不具备完成减数分裂的能力或者是由于染色体或纺锤体形成的信号转导异常。
最近,发表在国际顶级医学杂志《新英格兰医学期刊》上一项研究为揭开卵子成熟障碍背后的遗传机制提供了重要的线索。该研究发现一种编码微管蛋白的名为TUBB8的基因,如果该基因发生突变,则影响微管蛋白的组装,从而破坏卵子的微管网络,导致纺锤体无法正常形成,从而影响卵子的减数分裂和成熟发育,导致卵子成熟障碍。
总之言之,卵子获得减数分裂能力的过程需要关键调控酶和信号转导分子的转录和翻译,这些因子间复杂的相互作用,决定了卵子是阻滞还是进行依赖于信号因子的生成和靶向降解间的微妙平衡。最终观察到卵子成熟阻滞是卵子在分子水平功能失调,导致的卵子不具备完成减数分裂的能力或者是由于染色体或纺锤体形成的信号转导异常。
治疗手段
有了这种情况不要怕,不要慌!生育小讲堂把忙帮。首先,卵子成熟障碍同临床治疗中的用药和促排方案关系并不大,因为卵子成熟障碍主要是卵子本身发育过程产生了异常。而在卵子发育成熟的过程中,又涉及到多个基因不同时间的调控,因此卵子成熟具有复杂的调控网络,对其的研究则异常的艰难,所以目前关于卵子成熟障碍的机理并不是十分清楚,对于其治疗也没有十分有效的手段。
采用未成熟卵体外成熟培养技术(IVM),即将不成熟卵子放在专门的体外成熟培养液中进行培养至体外成熟,然后进行体外受精。但存在的主要问题是目前采用IVM技术的临床妊娠率仅10%~30%,显著低于正常50%左右的水平,并且,通过IVM也无法有效改善卵子成熟障碍患者的治疗结局。另外一个途径是采用供卵的方式,获取正常的卵子进行辅助生殖治疗。
话说的虽然容易,但是国内很多医院和医疗机构成功率却不高,而且碍于国内政策限制如何能确保根除卵子隐患,创造爱的奇迹呢?
遇到了上述情况不要怕,在这里我们会为您提供全方位辅助生殖解决方案!